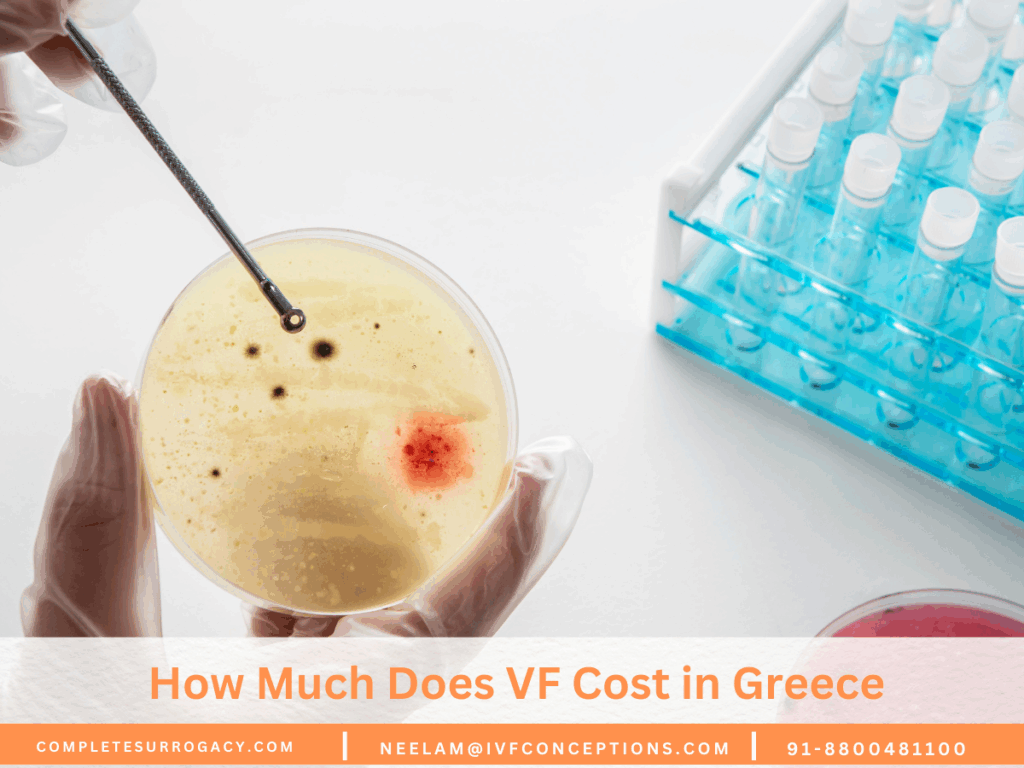
How Much Does VF Cost in Greece

IVF Egg Donation in the Czech Republic: Your Path to Parenthood

Ever thought about where caring fertility care meets top medical skills? The IVF with egg donation in the Czech Republic is one of the best options in terms of success rate and affordability of the fertility treatments. In the Czech Republic, fertility care is a mix of advanced tech, affordable prices, and top reproductive health […]
How Much Does IVF Cost in Georgia (Country): Your Comprehensive Guide

The IVF cost in Georgia ranges from $5,000 to $8,000 based on the types of services needed and the experience of the fertility doctor. Georgia (the country in Eastern Europe, not the U.S. state) is one of the most affordable and legally secure IVF destinations in the world. With a strong track record in assisted […]
How Much Does IVF Cost in Greece: Comprehensive Guides for IVF Patients
How Much Does IVF Cost in Greece? IVF in Greece has become one of the most sought-after destinations for affordable and high-quality fertility treatments in Europe. Known for its excellent medical infrastructure, transparent legal framework, and experienced fertility specialists, the country welcomes both domestic and international patients for IVF and egg donation cycles. 💰 IVF […]
IVF Cost in the Czech Republic: Affordable Options

The Czech Republic is one of Europe’s top fertility tourism destinations, known for its high-quality fertility clinics, transparent pricing, and favorable legal framework. Patients from across Europe, the UK, the US, and beyond travel to the Czech Republic for affordable IVF treatments, especially when seeking IVF with donor eggs. If you’re considering IVF in the […]
IVF Cost in Spain: What You Need to Know

Spain is one of the leading fertility destinations in Europe, known for its world-class IVF clinics, liberal reproductive laws, and wide access to fertility treatments for both locals and international patients. With high success rates, transparent pricing, and warm patient care, Spain has become a top choice for those seeking IVF or egg donation abroad. […]
Affordable IVF Costs in Pune: Find an IVF clinic with a High success Rate

Pune has quickly emerged as a leading fertility hub in India, offering world-class IVF treatments at highly affordable prices. With modern clinics, expert fertility specialists, and competitive rates, many couples are now choosing Pune over metro cities for their IVF journey. In this section, we break down the cost of IVF in Pune, what’s included, […]
IVF Cost in Hyderabad: What You Need to Know

Hyderabad is one of the top cities in India for advanced and affordable fertility care. With well-established IVF clinics, internationally trained doctors, and excellent success rates, Hyderabad has become a preferred IVF destination for couples across India and abroad. In this guide, we explore the IVF treatment cost in Hyderabad, what’s typically included, optional add-ons, […]
